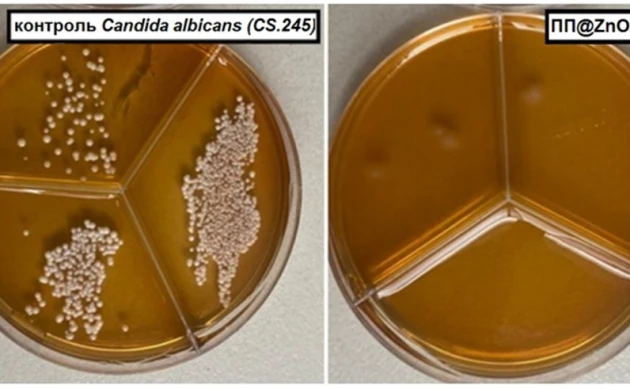
Томские ученые создали пленку для продолжительного хранения еды

Томские ученые создали пленку для продолжительного хранения еды
Ученые Томского государственного университета (ТГУ) и Института физики прочности и материаловедения (ИФПМ) СО РАН создали полипропиленовую пленку, которая способна подавлять рост бактерий и грибков при хранении пищи; разработкой уже заинтересовались крупные российские компании, сообщила в четверг пресс-служба вуза
ТОМСК, 29 янв – РИА Томск. Ученые Томского государственного университета (ТГУ) и Института физики прочности и материаловедения (ИФПМ) СО РАН создали полипропиленовую пленку, которая способна подавлять рост бактерий и грибков при хранении пищи; разработкой уже заинтересовались крупные российские компании, сообщила в четверг пресс-служба вуза."Физики ТГУ и ИФПМ СО РАН разработали инновационный материал для пищевой упаковки. Новая полипропиленовая пленка, модифицированная двухкомпонентными наночастицами оксида цинка и серебра (ZnO/Ag), способна эффективно подавлять рост патогенных бактерий и грибков на своей поверхности, уничтожая практически 100% микроорганизмов", – сказано в сообщении.Добавляется, что материал для пищевой упаковки позволит увеличить срок годности продуктов и снизить риск пищевых отравлений."У отечественной промышленности нет серийного многотоннажного производства антимикробных упаковочных материалов для пищевой отрасли. При этом производители очень заинтересованы в такой упаковке", – приводит пресс-служба слова старшего научного сотрудника лаборатории нанотехнологий металлургии физико-технического факультета ТГУ Ольги Бакиной.По ее словам, увеличение срока хранения продуктов даже на сутки приведет к существенному снижению экономических потерь. На данный момент интерес к технологии проявили крупные промышленные компании, среди которых "СИБУР ПолиЛаб" и НПП "Тасма"."Эффективность материала подтверждена в ходе тестов, рекомендованных стандартами. Пленку испытали против бактерий Staphylococcus aureus (золотистый стафилококк) и дрожжеподобных грибов Candida albicans, которые являются тестовыми организмами для оценки эффективности антимикробных материалов", – добавила пресс-служба.Уникальность материалаПо данным пресс-службы, уникальность разработки ученых связана с фотохимической активностью двухкомпонентных наночастиц ZnO/Ag. Под действием солнечного света или искусственного освещения они генерируют активные формы кислорода, которые разрушают компоненты бактерий и грибков."Ключевым элементом разработки стали двухкомпонентные наночастицы, синтезированные особым методом – электрическим взрывом двух скрученных проволок в среде смеси аргона и кислорода. Электрический взрыв обладает достаточной производительностью.., высокой чистотой и возможностью варьировать химический состав порошков. В свою очередь, состав смеси исключает наличие примесей на границе раздела фаз", – цитируется Бакина